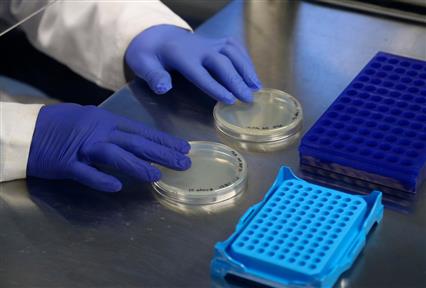

Περισσότεροι από 1000 δρομείς της Novo Nordisk Hellas έτρεξαν στον 42ο Αυθεντικό Μαραθώνιο Αθήνας για να «Αλλάξουν τον Σακχαρώδη Διαβήτη»
Η ομάδα “Run to Change Diabetes” της Novo Nordisk Hellas έστειλε ένα ηχηρό μήνυμα για τη σημασία της σωματικής άσκησης στην πρόληψη και διαχείριση του σακχαρώδους διαβήτη, αλλά και της παχυσαρκίας

Loading...
δημοφιλές τώρα: